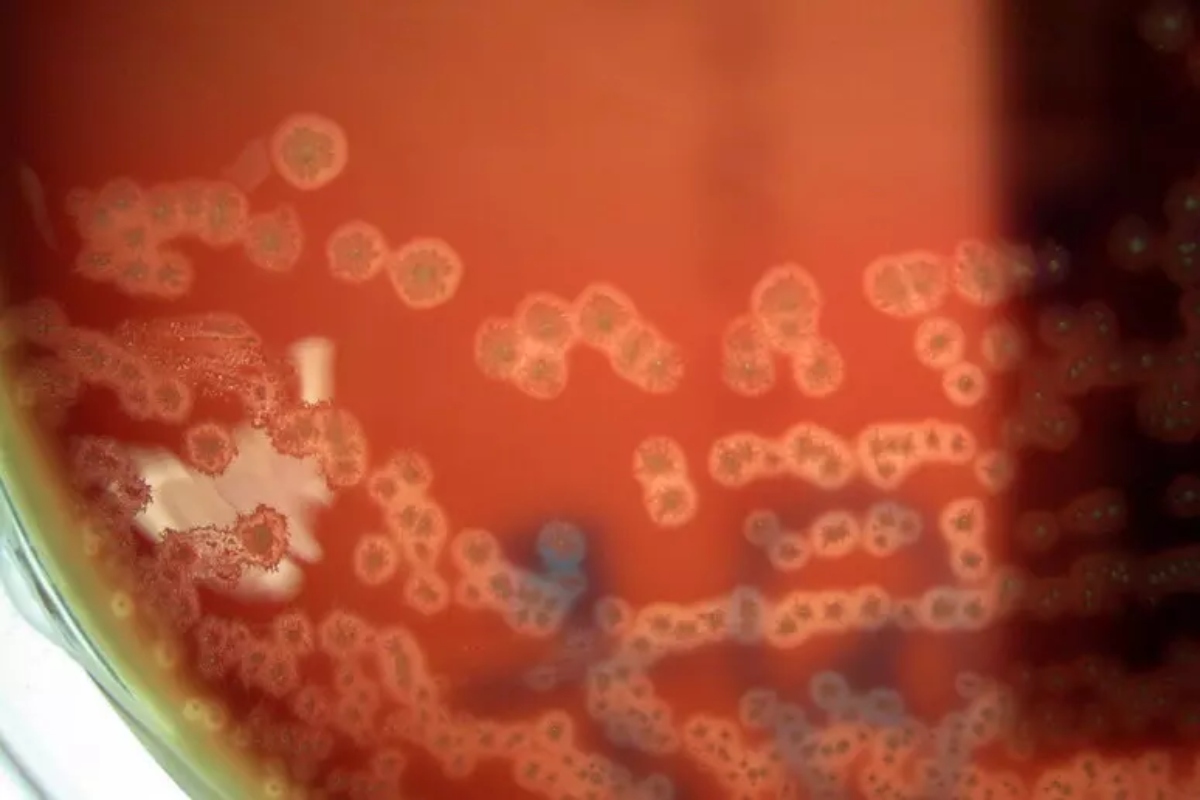
batteri mangia tumori

Lotta al cancro, abbiamo istruito i batteri a mangiare i tumori da dentro. I primi test in laboratorio (foto Ansa-Blitzquotidiano)
Batteri programmati per infiltrarsi nei tumori e divorarli dall’interno sono stati messi a punto dal gruppo di ricerca guidato dall’Università canadese di Waterloo, che ha pubblicato i risultati sulla rivista Acs Synthetic Biology.
Clostridium sporogenes modificati geneticamente
Questi batteri geneticamente modificati appartengono alla specie Clostridium sporogenes, che si trova comunemente nel suolo, e potrebbero diventare una nuova arma nella lotta al cancro, anche se i trial clinici sull’uomo sono ancora lontani.
Infatti, gli autori dello studio coordinati da Brian Ingalls puntano ora a iniziare i primi test pre-clinici, per valutare la sicurezza con esperimenti svolti in laboratorio e su modelli animali.
La parte centrale dei tumori solidi è un ambiente privo di ossigeno formato da cellule morte, dunque l’ambiente di crescita ideale per Clostridium sporogenes.
Questo punto di forza si trasforma, tuttavia, in debolezza quando il batterio raggiunge il margine esterno del tumore: qui comincia a entrare a contatto con l’ossigeno e muore prima di portare a termine la sua missione.
Per risolvere il problema, i ricercatori hanno innanzitutto aggiunto al Dna del microrganismo un gene proveniente da un suo parente più tollerante verso l’ossigeno.
Quorum sensing
Per evitare che, grazie al nuovo gene, il batterio crescesse in maniera indesiderata prima di arrivare al suo bersaglio, hanno poi trovato il modo di attivarlo solo al momento giusto.
Per farlo hanno sfruttato il fenomeno del ‘quorum sensing’, un meccanismo di comunicazione chimica utilizzato dai batteri per coordinarsi tra loro: solo quando C. sporogenes si è abbondantemente moltiplicato dentro il tumore, il segnale diventa abbastanza forte da attivare il gene.
“Utilizzando la biologia sintetica, abbiamo costruito qualcosa di simile a un circuito elettrico – commenta Ingalls – ma al posto dei fili abbiamo usato frammenti di Dna. Ogni frammento ha il suo compito: se assemblati correttamente, questi formano un sistema che funziona in modo prevedibile”.
